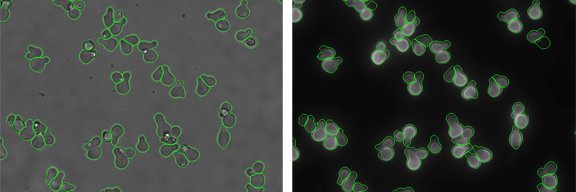
Dan Pollard Lab banner

Dan Pollard Lab
145 posts

Dan Pollard Lab
@dan_pollard_lab
Evolutionary genetics of gene expression at Western Washington University
Bellingham, WA Katılım Kasım 2016
221 Takip Edilen222 Takipçiler

Very excited to share our latest paper. Natural variation in codon bias and mRNA folding strength interact synergistically to modify protein expression in Saccharomyces cerevisiae academic.oup.com/genetics/advan…
English

Journal club paper today: Genome-wide base editor screen identifies regulators of protein abundance in yeast elifesciences.org/articles/79525
English

Journal club papers from a few weeks ago: Mechanisms of regulatory evolution in yeast ncbi.nlm.nih.gov/pmc/articles/P… Pleiotropic effects of trans-regulatory mutations on fitness and gene expression ncbi.nlm.nih.gov/pmc/articles/P…
English

Congratulations to Pollard lab member @benjamin_haagen for receiving the 2023 WWU Biology Graduate Teaching Assistant Award!
English

Am I correct that a college-level knowledge assessment on the biology of identity (race, sex, gender, and/or ability) does not exist? Instruments that even partially cover this topic would be very helpful. Thanks! @NeedhiBhalla @BrianMDonovan @jes_cerdena
English

Dan's band Spouse recorded this sad holiday classic over the weekend and released it today. Enjoy. spouse.bandcamp.com/track/have-you…
English

And thank you @ASCBiology for inviting us to put this event on!
English

Big thanks to the many eager and engaged participants and my awesome co-facilitators (Tom, @samjlord, & @FritzLaylin) who helped make the statistics workshop at #CellBio2022 a success!


English

Great to be at #ASCB2022 . Enjoyed learning about new proximity labeling methods from Alice Ting's keynote.
English

Next journal club paper: Barcoded bulk QTL mapping reveals highly polygenic and epistatic architecture of complex traits in yeast doi.org/10.7554/eLife.…
English

Come be my colleague at WWU! We have four biology-related tenure track positions open: (1) Molecular Cell Bio w/ Biomedical Focus, (2) Terrestrial Ecology, (3) Biochem, & (4) Chem/Biochem/Sci Ed. Review begins Sept 19th! hr.wwu.edu/careers-faculty
English

Preprint up of @AWienecke, Maggie Barry, my paper: Natural variation in codon bias and mRNA folding strength interact synergistically to modify protein expression in Saccharomyces cerevisiae biorxiv.org/content/10.110…
English

Check out this EP recorded by Pollard lab member Sam Herr during his senior year: open.spotify.com/artist/0fXTzBf…
English

@NeedhiBhalla Very sorry to hear about the pushback but thank you so much for sharing this. We are working addressing race, sex/gender, and ability throughout our curriculum and being prepared for pushback directed at specific instructor identities sounds critical.
English

Next journal club article: Genetic Analysis of Variation in Transcription Factor Binding in Yeast ncbi.nlm.nih.gov/pmc/articles/P…
English